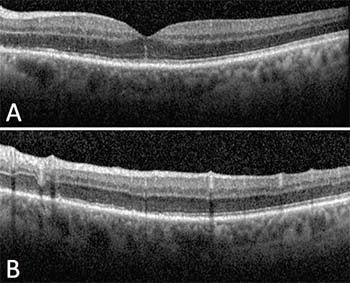

Medical History
His ocular history included radial keratotomy (RK) and cataract surgery in both eyes, and posterior vitreous detachment with multiple associated retinal tears in the right eye, which was treated with laser retinopexy about a year earlier. His medical history was unremarkable. Medications included ibuprofen, omeprazole and sildenafil. He denied any recent illness. Review of systems was negative.
Examination
Visual acuity was 20/15 in the right eye and 20/100 in the left, improving to 20/40 on pinhole. Intraocular pressures were 16 and 18 mmHg in the right and left eyes, respectively. No afferent pupillary defect was detected. Visual fields were full to confrontation in each
 |
| Figure 1. Color fundus photography (A) demonstrates multiple deep yellow-white lesions of the left eye, which correspond to hyperautofluorescence on fundus autofluorescence (B) and hyperfluorescent wreath-like lesions on fluorescein angiogram (C). |
Anterior segment exam showed bilateral corneal RK scars and posterior chamber intraocular lenses in good position, but was otherwise unremarkable. Dilated funduscopy showed a Weiss ring in both eyes, with pigmented laser surrounding retinal breaks in the right eye. The left eye had granular mottling of the foveal retinal pigment epithelium (RPE) and scattered deep yellow-white retinal lesions in the posterior pole and mid-periphery (Figure 1A) with mild to moderate retinal venous tortuosity compared to the fellow eye, but this was stable compared to previous fundus photos. We found no untreated retinal breaks on 360° scleral depression.
Diagnosis, Workup
Fundus autofluorescence (FAF) of the right eye was normal. The left eye had hyperautofluorescent areas corresponding to the yellow-white dots on color photos and clinical exam (Figure 1B). Fluorescein angiogram (FA) showed late hyperfluorescence of these lesions as well as mild leakage at the disc (Figure 1C). Optical coherence tomography (OCT) of the right eye was unremarkable but showed diffuse irregularity and patchy loss of the ellipsoid zone in the left eye (Figure 2).
Based on the patient’s complaints and history of multiple retinal breaks in the right eye, we initially had high suspicion for a similar process in the left. However, exam findings and subsequent imaging led to a differential diagnosis that included infectious and noninfectious choroiditis. Complete blood count with differential, comprehensive metabolic panel and syphilis serologies were unremarkable.
Treatment
Given the classic findings on the fundus exam, OCT, FAF and FA, we diagnosed multiple evanescent white dot syndrome
|
| Figure 2. Spectral-domain optical coherence tomography (SD-OCT) of the left eye through the fovea (A) shows irregularity of the ellipsoid zone and a linear hyperfluorescent line extending into the outer nuclear layer. Through the superior macula (B), SD-OCT demonstrates irregularity and focal disruption of the ellipsoid zone. |
Discussion
While the patient’s complaints and history of retinal tears in the fellow eye were concerning for a new retinal tear in the left eye, a careful exam and judicious workup led to the diagnosis of MEWDS. First described in 1984, MEWDS is one of the several inflammatory chorioretinopathies known as white dot syndromes. These disorders have an unknown etiology but tend to affect young, healthy patients who present with photopsias, blurry vision, floaters, dyschromatopsia or scotomas. Funduscopic exam reveals characteristic yellow to white lesions that can affect the retina, RPE, choriocapillaris or choroid.1
MEWDS mostly affects young, healthy women and often appears in patients with moderate myopia. Although usually unilateral, authors have reported bilateral or recurrent disease. Funduscopic exam reveals multiple deep, white-to-yellow dots in the posterior pole of 100 to 200 μm or more in diameter. The number of dots can vary and they may be absent altogether. When present, the white dots tend to resolve within seven to 10 weeks. A pathognomonic yellow-orange granularity of the fovea may persist after resolution of other findings and symptoms. Other findings may include vitreous cell, optic disc edema and an afferent pupillary defect.1–3
Role of Ancillary Imaging
Ancillary imaging may aid in the diagnosis of MEWDS. Authors have reported that chorioretinal lesions are more numerous and easier to identify on FA, FAF and indocyanine green angiography (ICGA) than on clinical exam or color fundus photos.2,4 FAF demonstrates increased autofluorescence of the lesions with surrounding hypoautofluorescence. Early phase FA reveals punctate hyperfluorescence in a wreath-like pattern, while later stages may show multifocal areas of mild staining. ICGA shows hypocyanescent lesions in later phases and usually more lesions than FA.2–4
Spectral-domain OCT through the fovea reveals irregularity or even disruption of the ellipsoid zone, which may also appear elsewhere in areas corresponding to other known lesions. As in this patient’s case, hyper-reflective lines or spots may also extend to the outer nuclear layer2,4.
Lesions seen on FA and ICGA have been classified as either “dots” or “spots.” Dots are smaller (approximately 100 μm) and show the classic wreath-like configuration of hyperfluorescence on early phase FA. Spots are larger (<200 μm), stain late on FA, and are hypofluorescent on ICGA and hyperautofluorescent on FAF.
Francesco Pichi, MD, and colleagues demonstrated that when evaluated with en-face OCT, the dots and spots localize to the outer nuclear layer and the ellipsoid zone, respectively.4 This may help elucidate the pathophysiology of MEWDS, which they propose is an inflammation of the photoreceptors leading to loss of the inner and outer segments of photoreceptors. They supported this by the fact that they did not see any abnormality of the choriocapillaris on en-face OCT. Marcela Marsiglia, MD, and colleagues also found no evidence of a primary disorder of the choroid, choriocapillaris or RPE in their multimodal imaging study and
 |
MEWDS, because of its self-limiting nature, usually does not require treatment. Rarely, patients may develop choroidal neovascular membranes, which anti-VEGF injections may treat effectively.1 RS
REFERENCES
1. Crawford CM, Igboeli O. A review of the inflammatory chorioretinopathies: the white dot syndromes. ISRN Inflamm. 2013:783190.
2. Marsiglia M, Gallego-Pinazo R, Cunha de Souza E, et al. Expanded clinical spectrum of multiple evanescent white dot syndrome with multimodal imaging. Retina. 2016;36:64-74.
3. Dell’Omo R, Pavesio CE. Multiple evanescent white dot syndrome (MEWDS). Int Ophthalmol Clin. 2012;52:221-228.
4. Pichi F, Srvivastava SK, Chexal S, et al. En face optical coherence tomography and optical coherence tomography angiography of multiple evanescent white dot syndrome: New insights into pathogenesis. Retina. 2016;36 Suppl 1:S178-S188.



